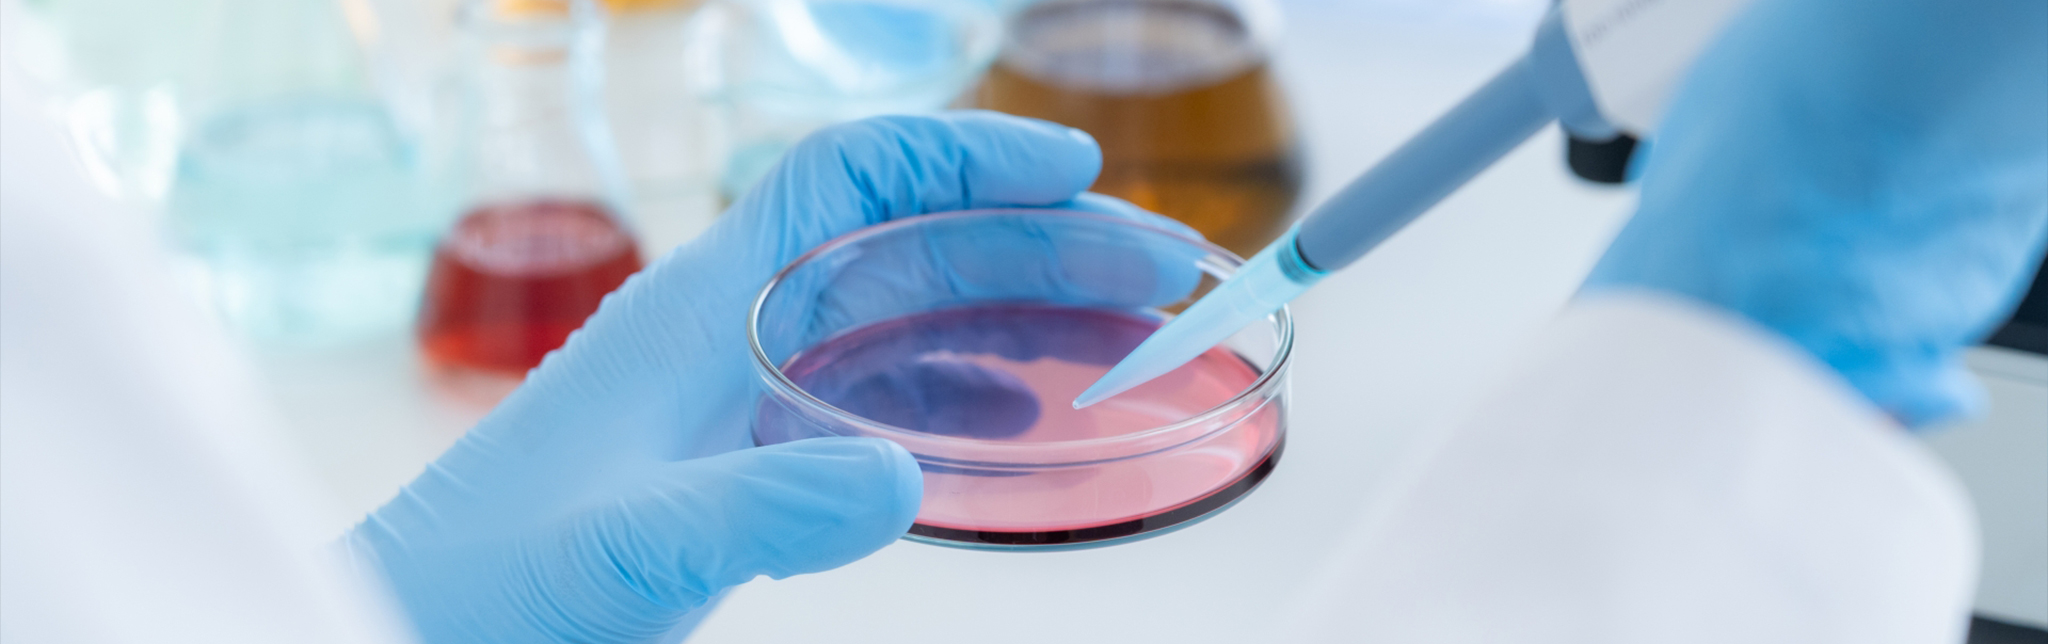

滅菌バリデーション
滅菌医療機器の場合、規格(JIS T 0806)に基づき、滅菌バリデーションを実施する必要があります。その他の製品でも規格に基づいてバリデーションを実施することにより、滅菌を保証することができます。照射の実用化までをご説明します。
①最大許容線量を決める
最初に確認が必要なことは、製品にガンマ線照射して問題ないか確かめることです。ガンマ線滅菌に適さない素材もありますので、放射線による高分子変化、耐放射線材料を参考に材質の選定を行ってください。
確認は、試験サンプルに想定される滅菌線量の倍線量以上を照射して行います。医療機器の場合、滅菌線量は25kGyが一般的ですので、その倍の50kGy以上を照射します。50kGy以上照射したサンプルで問題ないことが確認できれば、最大許容線量は50kGyとなります。最大許容線量は一次包装を含め確認する必要がございます。
最大許容線量で処理した場合でも、製品はあらかじめ定めた有効期間中、機能的な要求事項に適合しなければならない。
(JIS T 0806-1 8.1.1)
照射直後と6か月以上経過後の性状、強度試験等 材質劣化に関するデータが必要。
(薬食機発第0216001号)
医療機器として申請する場合、6か月以上経過後のデータも必要になります。早くからの準備・試験が必要になりますので、ご注意ください。
②最小線量(滅菌線量)を決める
JIS T 0806-2に基づき、滅菌線量を設定します。詳細方法は滅菌線量設定方法をご確認ください。
③線量分布試験を実施する

ガンマ線照射時には専用の容器(照射容器)にお客様の製品を充填します。この照射容器に、等間隔に線量計を取り付けた製品を充填し、ご要望の線量範囲内で照射できることを確認します。
確認するデータは3回以上繰り返した平均値を用いることが、規格で要求されています(JIS T0806-3 10.2.8)。
重量と寸法が同じであれば線量分布試験にダミー製品を使用することも可能です。



